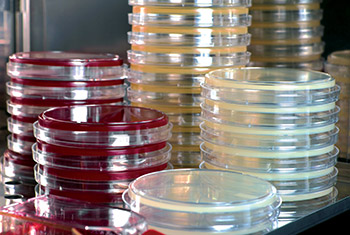

في أوائل القرن العشرين، ابتكر العالِم الروسي- الأمريكي ألكسندر ماكسيموف عبارة “الخليّة الجذعيّة” (stem cell) للاستخدام العلمي، وذلك ضمن عمله على موضوع تكوُّن الدم، حيث افترض أن جميع خلايا الدم تَنتُج عن خلية واحدة. وبعد عدّة عقود، في عام 1963م، ظهر الدليل المخبري على أيدي العالمين الكنديين جيمس تيل وإرنست ماكالوك، اللذين أثبتا وجود خليّة جذعيّة تتوالد ذاتياً في نخاع العظم، وتستطيع أن تتمايز إلى صفائح دمويّة، وكذلك إلى كريات دم بيض وحُمر.
فما الذي يعوّله الطب على هذا الاكتشاف وعلى الأبحاث الجارية في مجال الخلايا الجذعية؟
يتكوّن الجسم البشري من تريليونات الخلايا التي تتولَّد من بويضة واحدة مخصّبة، وهذه الخلايا تُستَبدَل بأخرى جديدة باستمرار. وكلما تقدّمنا بالعمر، تراجعت قدرة جسمنا على تجديد خلاياه، فينتج عن ذلك تعطيل عمل الأعضاء، والأمراض، وأخيراً الموت. وللحلم البشري بالشباب الدائم جذور عميقة في التاريخ. وتغذي هذا الحلم أمثلة مثيرة للخيال توفرها الطبيعة بكائنات تستطيع أن تعيد إنتاج الأعضاء التي تخسرها. أما في الطب فيعود وصف أول الأعمال الجراحيّة التي اعتمدت على قدرة الأنسجة على التجدّد، إلى عام 600 ق.م. حين وصف الجراّح الهندي ساسروتا أساليب تطعيم الجلد، لإصلاح شحمة الأُذُن وترميم الأنف. أما الفصل الأخير في هذه الرحلة الطويلة، فقد بدأ مع اكتشاف الخلايا الجذعية.
تعريف الخلايا الجذعيّة وأنواعها
تُعرَّف الخلايا الجذعيّة، من خلال ميزتين: قدرتها على إنتاج الخلايا نفسها بلا حدود، وهذا ما يُعرَف بالتجدّد الذاتي، وقدرتها على التمايز إلى أنسجة بالغة متباينة ومتخصّصة، وهذا ما يُعرَف بالقدرة (potency).
وبناءً على ذلك، يتم تصنيف الخلايا الجذعية في تسلسل هرمي ذي طيف واسع من القدرة. في ذروة الهرم، توجَد الخلايا الجذعيّة “الكاملة القدرة”، التي تنشأ حين تُخصَّب البويضات بالحيوان المنوي، فينتج عن هذا التخصيب تمكينها من توليد كل أنواع خلايا الجسم، بالإضافة إلى نسيج خارج الجنين يتضمّن المشيمة والحبل السُرّي. وفي المقابل، تحتفظ الخلايا الجذعيّة “المتعدّدة القدرة” بمقدرتها على إنتاج كل أنواع خلايا الجسم، إلا الأنسجة التي هي خارج الجنين. وأبرز أمثلة على ذلك، الخلايا الجذعيّة التي تُنتج جنيناً مكتمل التطور.
والمثير للاهتمام، أن تعدّد القدرة هو من الخصائص التي يمكن أن نجدها في أساليب أخرى مثل التحويل الذري، والانصهار الخلوي، وما استجد أخيراً، من إعادة البرمجة المباشرة للخلايا المتباينة ختامياً مثل تحوّل خلايا الجلد إلى خلايا تشبه تلك المتعدّدة القدرة، المعروفة أيضاً بالخلايا الجذعيّة المتعدّدة القدرة المستحَثَّة.
ومن خلال التأثير الغالب الذي تمتلكة أربع جينات محدّدة، تَمكَّن الحائز جائزة نوبل عام 2012م، الياباني شينيا يمناكا وزملاؤه، من تحويل خلايا فأر ناضج وخلايا بشرية إلى خلايا جذعية. ونتج عن هذا العمل أسلوب لإنتاج خلايا جذعية ذاتية متعدّدة القدرة، مع إمكان استخدامها كعناصر علاجية، سواء في الأمراض الانحلاليّة أو الأمراض الوراثيّة، من غير الحاجة إلى تعطيل نظام المناعة، الذي هو ضروري عند استعمال خلايا جذعية غير ذاتية. علاوة على هذا، مكّن العمل المذكور آنفاً من إنشاء منصة لنمذجة الأمراض، يمكن من خلال استعمالها فهم الأمراض المعقدَّة.
وعندما نهبط إلى قاعدة الهرم، تنخفض القدرة، مع ازدياد التلازم مع الأنسجة المحدّدة، وتُعرَف هذه الخلايا بالخلايا الجذعيّة المتعدّدة القدرة، أو الخلايا الجذعيّة البالغة، التي تُنتج أنواعاً مختلفة من الخلايا المختصة بنسيج معيَّن، مثل خلايا الدم الجذعيّة، التي تنتج بدورها جميع أنواع خلايا الدم.
الأنواع الحاليّة الراسخة
للمعالجة بالخلايا الجذعيّة
من أكثر أنواع المعالجة بالخلايا الجذعية شيوعاً هو زرع نخاع العظم، الذي يعتمد على قدرة خلايا الدم الجذعية، على إعادة إنتاج جميع أنواع خلايا الدم.
ونخاع العظم هو نسيج إسفنجي، موجود داخل عظامنا، مثل عظام القَص والحوض، ويتكوَّن من خلايا دم في مختلف مراحل تمايزها، بالإضافة إلى أنواع داعمة من الخلايا، مثل الخلايا الدهنية والمزِنْشيمية “خلايا اللحم التي يمكنها أن تتمايز لتكوين لحم أعضاء مختلفة في الجسم”.
وعند البشر، يُعدّ نخاع العظم الموقع الأول لتكوين الدم الجديد. وقد حدثت أول جراحة عصرية الأسلوب، لزرع نخاع عظمي، عام 1957م، وقام بها الحائز جائزة نوبل توماس إ. دونال، في معالجة قصور في النخاع العظمي بسبب تعرّض للإشعاع، بعد استخدام القنبلة الذريّة في الحرب العالمية الثانية. وقد مات في النهاية كل المرضى الستة الذين عولجوا بالزرع في غضون 100 يوم بسبب عدم معرفة دور نظام المناعة الذي أدى إلى رفض أجسام المرضى خلايا المانحين، التي لم تتجانس يومئذ مع خلايا المتلقّين.
يتكوّن الجسم البشري من تريليونات الخلايا التي تتولَّد من بويضة واحدة مخصّبة، وهذه الخلايا تُستَبدَل بأخرى جديدة باستمرار.
وعلى الرغم من ذلك، لم يُعرَض تماماً عن هذه الممارسة، فاستمرت في التطور حتى صارت معالجةً معهودةً يمكنها أن تُستَخدَم في معالجة طيف واسع من الأمراض، من أورام الدم الخبيثة، إلى أمراض المناعة الذاتيّة، وأعراض قصور النخاع العظمي، والأمراض الوراثية، مثل الثلاسيميا، وفقر الدم المِنجلي. ويمكن لزرع النخاع العظمي، أن يكون ذاتياً، حين تُؤخذ الخلايا الجذعية من المتلقّي نفسه، أو تكون من مانح متجانس، إذا أُخِذَت الخلايا الجذعيّة من مانح قريب، أو من غير الأقرباء حين يكون التجانس المناعي بين المتلقي والمانح متوافراً.
في الممارسة الحالية، يمكن استخلاص خلايا الدم الجذعية، مباشرة من نخاع العظم، أو يمكن تحريكها من النخاع العظمي إلى شرايين الدم القريبة، باستخدام عوامل صيدلية محدَّدة، تسهِّل عملية الاستخلاص. وثَمَّة مصدر ثالث لخلايا الدم الجذعية، هو الحبل السُرّي الذي يمتاز بمعيار تجانس مناعي واسع النطاق، بفضل طبيعة الخلايا المزروعة البسيطة. لكن عقبة كبيرة تواجه الاستفادة من الخلايا الجذعية المستخلَصة من الحبل السُرّي، هي عدد الخلايا المتوافرة المحدود، في الحبل الواحد. ويمكن تجاوز هذه العقبة باستخدام وحدتي دم من حبلين سُرّيّين للمتلقّي الواحد، أو تطوير استراتيجيات لتنمية الدم المستخلَص من الخلايا الجذعية، خارج الجسم البشري.
إن مناقشة هذا الأمر تثير مسألة مهمة تواجه كثيراً من العائلات التي تنتظر مولوداً: “هل علينا أن نحفظ في بنك أعضاء دمَ الحبل السُرّيّ، لطفلنا الوليد؟ وإذا كان الجواب إيجابياً، هل علينا أن نحفظه في مؤسسة عامة أو خاصة؟”.
الرد على هذين السؤالين متعدِّد ويتوقّف على عوامل كثيرة، مثل تاريخ الأسرة الطبي، والتكلفة المالية، والمكان الجغرافي، والتكوين الإثني، بالإضافة إلى توافر مؤسسـات لحفـظ دم الحبـل السُـرّي. ولا بد من الإشارة إلى أن الفارق الأساسي بين البنوك العامة والخاصة، هو أن الدم المحفوظ يكون في البنك العام متاحاً لأي مريض يحتاج إليه، أو متاحاً لأغراض الأبحاث، فيما يُحصَر استخدام الدم المحفوظ في البنك الخاص، بالشخص المانح، أو أحد أقربائه.
وبشكل عام، تشجِّع المنظمات الطبية الرسمية على حفظ دم الحبل السُرّي في المؤسسات العامة، لا المؤسسات الخاصة، لأسباب عديدة منها أن التكلفة في البنوك العامة هي صفر. أما في البنوك الخاصة، فعلى الأسرة دفع تكلفة قبول الدم أولاً، بالإضافة إلى أجر سنوي. وفوق هذا، ليس من ضمانات أن دم الحبل السُرّي المحفوظ سيكون في حالة جيدة عند الحاجة إليه، إذ ليس ثّمَّة معلومات كافية متوافرة في شأن الحفظ في المدى الطويل، وأثره في الخلايا الجذعيّة. كما أن احتمال أن الخلايا المحفوظة ستُستخدَم في معالجة مريض، هو احتمال أعلى بكثير في البنك العام، بالمقارنة مع البنك الخاص، حيث الاحتمال أن تحتاج أسرة المانح نفسه يوماً ما إلى زرع خلايا جذعية، هو احتمال ضئيل جداً، إلا إذا كان تاريخ الأسرة الطبي يشير إلى غير ذلك.

المعالجات الاختبارية بالخلايا الجذعيّة
باستثناء خلايا الدم الجذعيّة، تبقى كل أشكال معالجات الخلايا الجذعيّة الأخرى اختباريّة، أو أنها غير منتشرة شعبياً على نطاق واسع. ومن الأمثلة على ذلك استخدام الخلايا الجذعيّة المزِنشيميّة. فلهذه الخلايا غير الدموية القدرة على التجدُّد الذاتي وإعادة إنتاج نسيج الهيكل العظمي والغضروف والدهن. ومع أنها اكتُشِفَت في نخاع العظم، يمكن عزلها أيضاً من أنسجة أخرى، مثل الدهن، والمشيمة، والحبل السُّرّي. وقد أدت النتائج المشجّعة في نماذج الأبحاث قبل السريرية، إلى جعل الخلايا الجذعية المزِنشيمية من بين أكثر أشكال معالجات الخلايا الجذعية شعبية في التجارب السريرية لطيف واسع من الأمراض. غير أن النتائج التي أفضت إليها هذه التجارب لم تبلغ ما كان يؤمل منها، في النماذج قبل السريرية.
وباستثناء اليابان، ليس من تصريح رسمي لتسويق المعالجة بالخلايا الجذعية المزِنشيمية في الولايات المتحدة أو أوروبا، وهي غير متوفرة إلا من خلال تجارب سريريّة. وقد تحول الغرض في كثير من الدراسات الحالية، من إمكانات الخلايا المزنشيمية الجذعية لمعالجة الأمراض الانحلالية، إلى قدرتها على تحسين نظام المناعة، وتعزيز عملية الشفاء من خلال الجزيئات التي تفرزها.
ويمكن عزوُ فشل هذه المعالجة المؤسسة على الخلايا الجذعيّة، إلى عوامل كثيرة. على الأخص، كان أحد الأسباب الافتقار إلى بروتوكولات منسقة وموحّدة، لعزل الخلايا المزنشيمية الجذعية، وتنميتها خارج جسم الإنسان، بالإضافة إلى عدم تجانس الأنسجة المستخدمة مصدراً لهذه الخلايا. والحق أن استخدام الخلايا المزنشيمية الجذعية في التجارب السريرية كان غير ناضج، وجرى قبل الوصول إلى معرفة أصولها الخلوية، وبيولوجيتها الأساسية. وهذه العوائق تعالَج الآن، من خلال استعمال تكنولوجيات حديثة، تتيح تصنيف الخلايا المزنشيمية الجذعية في أنسجتها الأصليّة.
المصادر الأخرى للحصول على خلايا جذعيّة لاستخدامها في أغراض علاجية، هي الخلايا الجذعية الطرفية، التي تعيد إنتاج القرنية في العين، وهي أول خلايا جذعية علاجيّة أعطيت الموافقة على تسويقها تجارياً في أوروبا، بالإضافة إلى خلايا بشرة الجلد الجذعية، المسؤولة عن تجديد الجلد.
وبينما كان زرع الجلد مستخدَماً منذ سنوات، فإن البرهان العلمي لم يظهر إلا أخيراً، على أن خلايا بشرة الجلد الجذعية هي التي تتولى إعادة تجديد الجلد في عمليات الزرع هذه. وقد تمكّن فريق إيطالي/ ألماني يقوده ميشال دو لوكا، من معالجة صبي صغير من مرض جلد كاسح، سببه الافتقار إلى بروتين أساسي وضروري لحفظ سلامة الجلد. فقد انتُزِعَت خزعة من جلد الولد المريض، واستُخلِصَت من الخزعة خلايا، وعُدِّلَت جينياً في المختبر من أجل استعادة البروتين المفقود. وبعد ذلك، تمكَّنت الخلايا المعدَّلة من الحلول مكان جلد المريض عند زرعها. ووَجدت الدراسة التي أُجرِيت على المريض، بعد الزراعة، أن الخلايا المزروعة أولاً قد ماتت، إلا أن خلايا جذعية نادرة من الجلد، موجودة في الزرع، تولّت إعادة إنتاج الجلد السليم. واستناداً إلى هذا النجاح المدهش لهذه الوسيلة الطبية، تتوالى الدراسات الآن من أجل تحسين الجدوى، وتقييم احتمالات السلامة المتعلّقة بمعالجات خلايا الجلد الجذعية، لفتح المجال أمام استخدامها في طيف واسع من أمراض الجلد، مثل الالتهابات الحادة والحروق.
وإضافة إلى استخدام خلايا جذعيّة بالغة، أفضت التقارير أخيراً، عن قصص نجاح استخدام الخلايا الجذعية الجنينية، أو الخلايا الجذعية المُستَحَثّة المتعدِّدة القدرة، إلى تأسيس شركات ناشئة، غرضها إقامة قنوات تتيح إنتاجاً تجارياً سليماً لمثل هذه المعالجات، بطريقة تلتزم المعايير الصارمة التي تفرضها الوكالات المنظِّمة. ومن أمثلة هذه المعالجات، استخدام خلايا جذعية جنينية أو خلايا جذعية مستحَثَة متعدّدة القدرة، من أجل: إعادة إنتاج شبكة العين وترميمها، لمعالجة العمى، وترميم جروح النخاع الشوكي، وأيضاً إنتاج خلايا “بيتا” (المنتِجَة للإنسولين في البنكرياس) تُبَرشَم وتُزرَع تحت الجلد، لمعالجة مرض السكّري من الفئة الأولى.
لقد شهدت العقود القليلة الماضية خطوات تقدّم واسعة في مجال فهمنا للبيولوجيا الأساسية للخلايا الجذعية، وكذلك في ميدان تطوير تقنيات جديدة توسع لهذه الخلايا احتمالات الاستفادة منها.
لقد شهدت العقود القليلة الماضية خطوات تقدّم واسعة في مجال فهمنا للبيولوجيا الأساسية للخلايا الجذعية، وكذلك في ميدان تطوير تقنيات جديدة توسع لهذه الخلايا احتمالات الاستفادة منها. وتُحدِثُ مثل هذه التقنيات، كمعالجة الجينات، وتعديلها، بالتضافر مع الخلايا الجذعيّة، ثورةً في أسلوب معالجتنا كثيراً من الأمراض، وفي توفير أدوية لأمراض كانت في الماضي تُعَدّ غير قابلة للعلاج.
وآخر الأمثلة هو استخدام المعالجة الجينيّة بخلايا الدم الجذعية، لعلاج فقر الدم الخلوي المنجلي، الذي هو مرض موهِن، يسبب مشكلة اقتصادية هائلة في البلدان التي يتوطن فيها المرض. لكن من المؤسف أن الحماسة الشديدة للمعالجات المؤسَّسة على الخلايا الجذعيّة، تخلط الحدود بين ما صار ثابتاً ومُقَراً، وبين الأمور التي لا تزال محل اختبار. وأدى هذا الخلط إلى نشوء مؤسسات تجارية تسوِّق معالجات خلايا جذعية غير مصرّح بها، وغير منظَّمة بعد، وتدّعي أن في هذه المعالجات الشفاء من قائمة طويلة من الأمراض، وهي في الحقيقة مصدر قلق هائل على سلامة المرضى.
ولا بد، حين ننظر في أنواع هذه المعالجات، من طرح سؤال أساسي: هل المعالجة معتمدة لدى الوكالات المنظِّمة، للحالات التي تُستَخدَم من أجلها؟ وإذا لم تكن كذلك، هل هي جزء من تجربة سريريّة، عليها إشراف جيد ومراقبة من هذه الوكالات المنظِّمَة؟
ختاماً، وإن كان يجب الامتناع عن تقديم الخيال العلمي للمرضى على أنه معالجة، إلا أن هذا الخيال العلمي يمكنه أن يكون خارطة طريق توجه الأبحاث في شأن المعالجة بالخلايا الجذعية، حتى تبلغ أقصى ما تنطوي عليه من إمكانات.